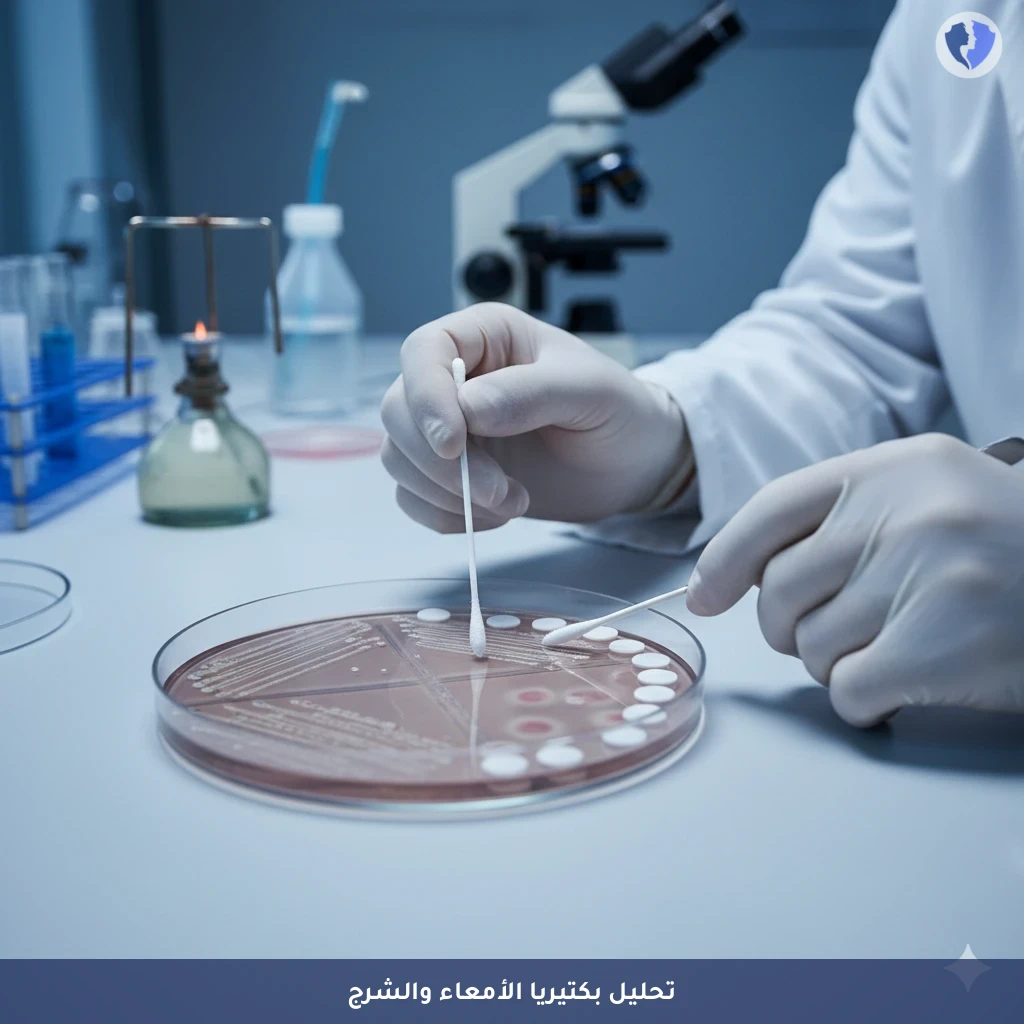
مسحة ومزرعة المستقيم - مسحة ومزرعة من الشرج

تفاصيل الخدمة
مسحة ومزرعة المستقيم - مسحة ومزرعة من الشرج
فحص ميكروبيولوجي تشخيصي يتم فيه جمع عينة من داخل المستقيم باستخدام مسحة معقمة خاصة. تُزرع العينة على مجموعة من الأوساط الانتقائية والتفريقية للعزل الأولي للبكتيريا المعوية المسببة للأمراض. الهدف الأساسي هو عزل وتحديد مسببات الأمراض البكتيرية (مثل السالمونيلا، الشيجيلا، العطيفة، الإشريكية القولونية النزفية)، مع إجراء اختبار الحساسية للمضادات الحيوية (Antibiogram) لتوجيه العلاج. كما يُستخدم للكشف عن حاملي البكتيريا المقاومة مثل بكتيريا CRE أو MRSA في المستقيم.